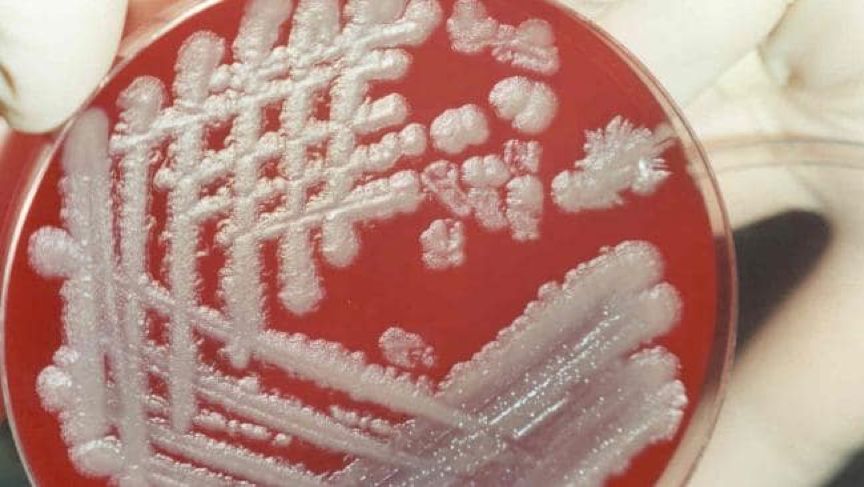

-
日期: 2020-03-03 | 来源: 大象公会 | 有0人参与评论 | 字体: 小 中 大
从非典到新冠肺炎,中国多次疫情中,都有不少人认定病毒是人造武器——特别是美国制造的生化武器。虽然迄今为止的每一次病毒基因溯源,都有很强的证据指向它们属于自然界变异,但仅仅强调这一点,并不能打消很多人的疑虑。
本文的目的是介绍生物武器相对鲜为人知的现状,了解这一现状,「生化武器论」的荒谬也就不言自明。它包括以下几点:
a. 在生物科技较为发达的主流国家,生物战已是相对过时的概念,大家都严重缺乏将生物武器实际装备、尤其是投放的驱动力。
b. 现阶段主流国家对于生物武器技术的直接研究仅限于维持相关能力,目的在于形成对等报复能力、实现威慑性平衡。
c. 在生物战略安全领域,落后国家对先进国家造成的实际威胁,远大于先进国家对落后国家的威胁。
让我们一步一步说。
生物武器从未实现过高水平杀伤能力
在人类历史上,使用生物武器的历史非常久远。比如在僵持不下的攻城战中,进攻方把尸体、特别是传染病患者的尸体作为武器丢入城内,类似行为在不同时期、不同的国家和民族战争史中,不胜枚举。
在近代之前,由于人类极度缺乏清晰有效的防疫手段,哪怕是「健康人」自身,特定条件下都足以形成强有力的生物武器。

· 经历了长期的进化淘汰(扛不住的都病死了)后,健康欧洲人身上携带的人畜共患病原体种类远高于印第安人。在对美洲的殖民过程中,印第安人死于欧洲人枪炮的比例非常低,90%以上是死于接触造成的传染病。即使是友善的共处,也足以引发对印第安人毁灭性的瘟疫
然而,违背普通人认知的是,越晚近的生物武器,能够造成的杀伤反而越小。
和其它武器(比如枪炮)的发展大趋势相反,随着人类在生物学和现代医学领域的快速进步,生物武器的硬杀伤能力在20世纪之后急剧下降,在今天已进入历史上最低谷时期。
现代生物武器诞生的初衷,是希望以廉价的方式造成尽可能大的杀伤。
任何由非生命物质所制成的实体弹药,杀伤力都会随着范围的增大而急剧下降——单个的炸弹、炮弹能装填的炸药或者化学战剂就那么多。试图用常规和化学武器实施战略打击,需要极为惊人的弹药数量和规模庞大的军队,成本过于昂贵。
20世纪早期,随着生物技术的发展,生物武器提供了突破困境的希望——理论上,通过致病微生物在感染目标后的不断繁殖和扩散,一颗炸弹导致一个城市的居民致病、并死亡大半,是完全可能的。
那么,拥有这种武器,只需要极少量的弹药和小规模的军队,就足以形成毁灭性的威慑和战略打击能力。直到今天,杀伤能力上的效费比潜在优势,仍然是生物武器研究者们不断强调自身重要性、争取更多经费投入的核心论据。

· 长崎上空核弹爆炸的瞬间。核武器在40年代的成熟,使生物武器彻底退出了战略摧毁力量的竞争
现代生物武器的研发,始于1900年之后的德法两国——它们是最早建立微生物学的国家;随后日本、苏联、英国、加拿大、美国等纷纷跟进。1918-1919年的西班牙流感席卷全球,导致2500-4000万人死亡,迫使一战提前结束,空前直观地展示了生物武器在杀伤能力上的前景。
因此在1920-1930年间,生物战理论发展到它的巅峰:各国试图将其发展为类似今天核弹头地位的战略性武器,其打击目标并不仅仅是包括平民的人,而是涵括农业作物、牲畜在内,致力于全面摧毁目标国家的整个基础体系。
英国生物武器创始人汉基在1925年写道:「以枯萎病摧毁农作物,以炭疽热杀死马匹,以鼠疫使整个地区而不单是军队受毒,这便是军事科学无情进展的路线」。
很多人觉得可以克敌制胜的「超越常规界限的作战理论」,和此类20世纪早期的西方战争理论相比,就是《读者》式的抒情散文。
但从1917年德国用间谍对协约国阵营的骡马接种鼻疽假单胞菌开始,直到1984年两伊战争中伊拉克对伊朗使用生物战剂,现代生物武器从来没有取得过预想中的杀伤效果,对正面战场的最终结局均不形成实质性影响。即使抗战中,侵华日军面对毫无对等报复能力,也完全缺乏防御能力的中国军民进行的大量生物战也不例外。

· 两伊战争中,伊朗军队死亡数十万人,而伊拉克的生物与化学武器合并导致伊朗5000多人受感染,而病死率在15%左右,造成死亡不到1000人
正如美国研究者查尔斯·史都华所言,现代的生物武器「与其说是致命性武器,不如说它是恐吓性武器。它们引起的恐慌与它们制造的伤亡是不成比例的。」
对于生物武器有限的杀伤效果,苏联的相关事故是一个极佳的讲解素材:
1979年,司维德洛夫斯克的生化武器工厂(代号「十九号大院」)因为通风过滤设备故障,导致武器级的炭疽芽孢泄露到空气中,并大量扩散到城市内。由于行政隔阂加上刻意的瞒报,城市官员直到一个星期后才确认突然爆发的传染病是炭疽热。这次泄露事故中,含有炭疽气溶胶的气雾导致近5000人遭受感染。

· 司维德洛夫斯克的炭疽气雾泄露分析图。苏联声称疫情是居民食用受自然界炭疽感染的动物肉类引发,但当地两名医生从克格勃的手中保存了组织样本和医疗记录,证实了死者死于吸入性的炭疽感染,而不是摄入食物引发的肠胃型炭疽
这已经是生物武器袭击中最理想的背景情况。在长达数天时间内,公共卫生系统的应急机制处于混乱低效状态,人工传染病顺利完成初期传播扩散。
但即使是这样,疫情确认后,仅依托二战后的常规公共医疗体系支持,靠服用大量抗生素,最终仅有约70人因此死亡,而且没有24岁以下的死者。
早已成熟的生物战防御体系
1979年的苏联炭疽泄露事故之所以未造成很多人预想的杀伤效果,核心的要素有两点。
相对次要的一点是,炭疽的传染和致病致死能力并不算太强。

· 炭疽的孢子
而最主要的一点是,二战之后,随着微生物的繁殖和传播模式被摸得越来越清楚,新的公共卫生体系建立,抗生素被大量应用,生物武器——特别是细菌类的生物战剂——的作战效能被极大的抑制,进入了人类历史上最低谷的时期。
比如志贺氏菌导致的痢疾,早年一直是战争中致死的重要因素,经常一场战争下来,因痢疾而死的人,远远超过刀剑枪炮下的亡魂。
但到了二战期间,它甚至连被当作生物战剂候选对象的资格都没有——因为当时通常的卫生防治措施,就足以有效的应对这种疾病。
实际上,针对生物武器的有效防御原则,直到今天都没有超出二战时期的理论框架基础。美国早在1942年的一项战时研究中,就提出了针对生物战的三级防御体系。
最基础的底层防御,是建立起广泛、完善的公共卫生体系,对贫民窟这样的人口聚居区,实现疫苗接种等防疫措施的普及,消灭瘟疫爆发的温床。
次一级的中间防御,是在各个企业、单位,建立常备或半常备的防疫措施,降低呼吸系统疾病和食物引发疾病的风险;其涉及到的大多数措施,在今天依然是标准配置,如喷洒消毒剂。

· FBI危险证据响应小组演示操作流程,生物安全与公共卫生体系不可分离的理论认识,在二战期间就已建立
最后一级防御适用于紧急情况下:政府将调动/扩充包括各医院在内的私营/公共卫生医疗设施以应对疫情;组织部队实施对媒介(如跳蚤/老鼠)的侦察和对污染的消除;设置流动的生物战医疗小组;划定和维持隔离区,从危险地带疏散未感染人群,分发口罩面具和药物,接种疫苗等等。
只要能满足这套体系的必要前提——信息能及时通畅地上下传达,人们有效参与(知道自己要做什么、为什么要这么做)防疫工作,在人类所知的范围内,无论何种厉害的生物武器,或者是突发的自然疫病,都能有效应对化解。
它们依然会导致一定数量的死亡,但不再可能实现对整个城市人口的结构性毁灭——即使是在缺乏疫苗和针对性药物的情况下。
当然,应急状态下社会秩序的全方面严厉管制,必然带来对经济和正常生活的压抑、破坏。基于这一点,生物武器的威慑性质实际上被完全改变了。

· 对社会秩序的严格管制,是切断疫情传播的杀手锏,但经济代价非常高昂
生物武器的最初研发目的,是要达到「毁灭整个国家的基础,将全国化为焦土,数十年内难以恢复」的效果;但在二战之后,它真正能实现的,却是「只要用了,你就要进入紧急管制状态,承受巨大的经济损失」。
花费了巨大的代价,在实际杀伤效能上完全无法达到令人满意的结果,而且政治名声还极其难听,这才是多数国家在60年代末、70年代初,放弃装备进攻性生物武器的真正原因——化学武器的名声并不比生物武器好听,但美国对化学武器的态度就完全不同,坚决不放弃装备。

· 炭疽感染。这张照片远不能充分展示炭疽感染可能引发的惨状——比如当它侵犯一个儿童的眼睛时。这种对大众感官和心理上的严重冲击,正是生物武器臭名昭着、以至于持有和使用它,所需政治代价极为高昂的核心因素之一
高昂的维持成本
论传播力、致病性、致死率、治疗难度,在人类所知的传染病中,炭疽即使是在20世纪五六十年代也早已排不上前列——合适的抗生素治疗方案,可以将它的死亡率降到极低。
然而,它依旧能成为各国生化武器库的绝对主力。这便涉及到生物武器专家最不喜欢对外坦诚的两件事:一,能合格成为武器的微生物少之又少;二,生物武器的长期、大规模维持费用极其昂贵。
要作为武器,它要兼具可靠的储存、运输、起爆扩散能力和环境适应性——散布后能耐受冷热气候和日照,这些条件足以剔除绝大多数微生物。
比如日本在二战期间,无法解决钢制弹体在起爆过程中,炸药的高温高压燃气导致炭疽杆菌和跳蚤(携带鼠疫杆菌的媒介)被高比例灭活的问题,最后只能采用陶制弹壳,以减少炸药用量——这使得炸弹在储存和运输中的安全性极差,根本不能说是合格的武器。

· 陶制外壳的石井炸弹。同期美国已经很好的解决了钢壳生物炸弹的技术突破,旧日本军的生物战技术水平相当差,在战后的秘密交易中,真正吸引美国人注意力的是大量的人体试验资料,这是英美加在本国无法获得的
炭疽杆菌拥有微生物中极其罕见的环境适应和生存能力,它的芽孢能在沸水中存活数小时,在不萌发的情况下可以存活数十年——后者是一个极其关键的要素。
除去身份有争议、经常被划分到化学武器类别的生物毒素武器(比如蓖麻毒素)以外,生物武器最大的特征就是,它们是活的生命体——无论是细菌还是病毒、又或是跳蚤老鼠,而且它们绝大多数都远没有炭疽杆菌这种变态的生存能力。
这就带来了生物武器面临的最大问题:储存寿命非常短。
绝大多数生物武器的半衰期,都在几个月到两三年之间——对于一些特别短命的生物武器,三个月的储存后,炸弹内的致病微生物和媒介就会死掉一半。半年后,就只剩下原来的四分之一。换句话说,生物武器廉价高效的前提之一,在于造出来马上就要用出去——这在非战争年代显然是不可能的。
细菌类的生物战剂,还可以用琼脂、肉汤等形成外部的营养环境,通过大规模的发酵和浓缩来进行制取,每公斤的造价通常还在可承受的范围内。
· 培养皿上的炭疽
但是病毒必须依靠宿主细胞中的资源来进行自身的复制、释放完整病毒颗粒;因此它的量产要通过鸡胚或者细胞来培养,所以病毒战剂价格比细菌战剂要高出2-3个数量级,少辄数百倍,多辄上千倍——与之类似的还有立克次体类战剂。

· 鸡胚广泛的用于微生物试验和生产
事实上,要维持一个大规模的生物武器库,储备必须常换常新,费用惊人的昂贵。
这进一步降低了生物武器的吸引力——如果十年下来都没机会用上,无法迫使对手进入紧急管制状态,那么对手没经济损失,自己倒是要年年大笔掏钱,这到底是谁在承受生物武器的攻击?
而且,细菌的传染、病毒的变异都是六亲不认的,不会跟人一样讲政治。在全球化时代,由于巨大的人员物资跨国流通量,各国在生物安全上都处于相互捆绑的状态。生物武器无论日常保管还是实弹投放,都存在危害自己人的危险。

· 1942年,英国曾在苏格兰东北部的格鲁纳德岛上测试炭疽炸弹。尽管炸弹始终未投入实用,实验却造成了危险且清理代价昂贵的炭疽污染。直至1986年,该岛的大规模清理才完成,1990年才解除封锁
一战之后,哪怕是造成数千万人死亡的二战期间,所有具备生物战报复潜力的国家都没有遭遇过大规模生物战。这使得和平时期的生物武器军备竞赛,越来越缺乏意义。
1969年,美国签订《国家环境保护政策法》,宣布永不使用生物武器,公开销毁了库存的数万枚生物武器炸弹,分离并无害化处理了数百公斤干燥炭疽杆菌和兔热病病菌、7.3万公斤麦锈菌和900公斤稻瘟菌,相关设施净化、设备拆除,连霍顿试验场都变成了旅游景点。
在这个基础上,美国进而推动了1972年的《禁止生物武器公约》,只保留防御性的研究内容——苏联也是缔约国。
这种看似自我阉割的做法,给美国带来了巨大而长远的实际利益。
生物武器研发有两个核心特征。其一,进攻性与防御性的研究是一体两面;其二,军用和民用的技术基础高度通用。保留防御性研究的真实含义,就是不装备、不使用生物武器,但不中断对前沿生物武器的前沿概念和技术研究,平时作为防御手段,到战时条约破裂,依然可以快速转型、研发制造出相应武器。

· B2战略轰炸机这样的武器,才是随时能拿得出手的核心战略打击力量
由此,美国节约了大量军事预算,还在国内和国际舆论上形成了显着的政治道义优势,对当时深陷越战泥潭的美国来说相当重要——这同样是持有生物武器必须考虑的成本。
苏联/俄罗斯正好可以作为反面教材:他们直到90年代苏联解体后都没有停止生物武器的批量生产和装备,又不敢真正投放在战场上,不仅耗费了大量的资金,而且还出现了1979年炭疽泄露的丑闻,为之付出了非常沉重的政治代价。
直到今天,司维德洛夫斯克泄露事件,是全世界每一个专业研究生物安全、尤其是生物恐怖袭击的人都必然要仔细分析和探讨的案例。每一个研究过这个案例的人,都会深刻的认识到苏联如何遵守它亲自签署的条约,如何对待本国的公民。
最大的生物安全威胁来源来自哪里
从1960年代开始,生物武器就长期处于一种强国划不来、弱国玩不转的尴尬境地。这才是1970年代初,生物武器被国际社会禁止的最根本原因。
发达国家普遍缺乏使用生物武器的意愿,一是全球市场经济形成的生物安全捆绑,二是普遍具备对等报复的生物战能力。
中国在九十年代之后的生物武器相关研究,也主要是以补课为主。比如美俄等国的标准生物战剂中,都包括了委内瑞拉马脑炎病毒。中国本土没有它的自然疫情,就要在实验室完成人工培育,进而掌握它的疫苗研发,形成完整的防御/报复能力。
即使是游离在全球市场体系外的特殊国家,统治者再怎么不在乎本国公民的生命安全,也须畏惧斩首性质的军事打击。这样的国家可能会研发、装备生物武器,不过大多数情况下,也只是为了增加一些讹诈的本钱。
倒是那些认定自己不管干什么失去的都只是枷锁的极端组织和个人,比起这些国家要危险得多。而且随着生物科技的快速扩散,获得和研发生物武器的门槛被大大降低,生物安全的威胁在这些方面开始显着增大。

· 美国陆军生物医学研究实验室的人员打开含有炭疽的信件。炭疽信件事件一度搞得美国上下鸡犬不宁,但造成的实际损失很有限
在1970-2014年间,全世界有143次大规模杀伤性武器使用的记录,生物手段出现了35次,绝大多数来自非国家行为体:比如1984年,美国境内一个印度文化派生的邪教,为了阻止俄勒冈地区很可能对该教不利的选举,从医药公司购买沙门氏菌并投放到多个饮食店面,导致近800人中毒。
但总体上讲,恐怖组织和个人的力量依旧非常有限,他们的生物袭击能造成局部的破坏和短时间的公众恐慌,却无法使一个国家处于长期、大范围的疫情状态,形成对国家基础的沉重打击——他们没有能力去决定整个国家的防疫体系如何运转。
近几十年以来,绝大多数在全球范围内造成巨大损失的疫情案例中,没有一个国家的防疫系统失能是因为恐怖袭击、或者发达国家的阴谋破坏所导致。正相反,在全球化市场经济的生物安全捆绑下,疫情往往会在落后国家完成前期的传播和爆发,然后扩散到先进国家。

· 猪瘟疫情在俄罗斯长期未能被有效控制,最终导致它的多个邻国遭殃
真正对全球生物安全威胁最大的,不是生物武器,而是部分国家防疫系统的失能。
结语
二战后,绝大多数国家先后放弃进攻性的生物武器研发和装备。这并不是源于道德感召,而是它带来的麻烦和风险,已经远远超出了可能的收益,以至于任何在政策制定时还能理性计算得失的大国,都不愿意再在这个方向上投入过多的经济和政治成本。
在今天,对于任何国家而言,只要它始终保持着对于军事生物武器的警惕性以及防御性研究,拥有报复性生物战潜力,就不会真正面临军事打击性质的生物武器威胁。人们真正遭遇过的生物威胁和灾难,无不源于社会管理问题和恐怖袭击。
应对生物威胁的关键在于保持防疫体系的高效率运作,它需要满足以下几个核心条件:畅通透明、不能被少数人所阻滞的多向信息传播;专业能力、岗位配置、决断权、责任划分、利益导向五大要素良好匹配的人员组织架构;及时、充足的物资供给。
生物武器之所以被各主流国家边缘化,是因为只有在对手的防疫体系瘫痪失能的情况下,它才能造成真正的灾难性后果。但对手的防疫体系是不是形同虚设,这件事取决于对手,不取决于自己。
细菌和病毒不能击败防疫体系,只有人,特别是自己人,才能让它们击败防疫体系。
[1]《医学生物侦检与防护技术概论》主编:潘欣
[2]《大规模杀伤性武器与恐怖袭击应对手册》作者:[美] charlse stewart
[3]《动物冠状病毒病》作者:云南省兽医防疫总站
[4]《防生物危害医学》主编:杨瑞馥
[5]《化学战剂毒理学手册》主编:[美] Ramesh C. Gupta
[6]《日本侵华决策史料丛编 生物武器作战》主编:[日]近藤昭二
[7]《日本侵华细菌战研究报告》主编:李忠杰
[8]《灾害救援医学》主编:[美]Gregory R.Ciottone
[9]《中国军事医学史》主编:朱克文
[10]《2017国际军备控制与裁军》主编:中国军控与裁军协会
[11]《猪病毒病》主编:姚龙涛
[12]《美国生物防御》作者:田德桥
[13]《生物恐怖防御》主编:黄培堂
[14]《十年来细菌性痢疾的防止概况》作者:谢少文
[15]《我军菌痢、肝炎防治研究进展概况》作者:黄玉兰
[16]《中疾控传防发〔2019〕 103 号》文件- 新闻来源于其它媒体,内容不代表本站立场!
-
原文链接
原文链接:
目前还没有人发表评论, 大家都在期待您的高见